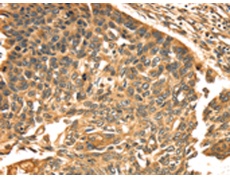
一抗

|
Background: |
The protein encoded by this gene is a membrane protein that catalyzes the addition of an alkyl group from an akylamine to a glutamine residue of a protein, forming an alkylglutamine in the protein. This protein alkylation leads to crosslinking of proteins and catenation of polyamines to proteins. This gene contains either one or two copies of a 22 nt repeat unit in its 3' UTR. Mutations in this gene have been associated with autosomal recessive lamellar ichthyosis (LI) and nonbullous congenital ichthyosiform erythroderma (NCIE). |
|
Applications: |
ELISA, IHC |
|
Name of antibody: |
TGM1 |
|
Immunogen: |
Synthetic peptide of human TGM1 |
|
Full name: |
transglutaminase 1 |
|
Synonyms: |
LI; KTG; LI1; TGK; ICR2; ARCI1; TGASE |
|
SwissProt: |
P22735 |
|
ELISA Recommended dilution: |
2000-5000 |
|
IHC positive control: |
Human esophagus cancer |
|
IHC Recommend dilution: |
25-100 |

 購物車
購物車 幫助
幫助
 021-54845833/15800441009
021-54845833/15800441009